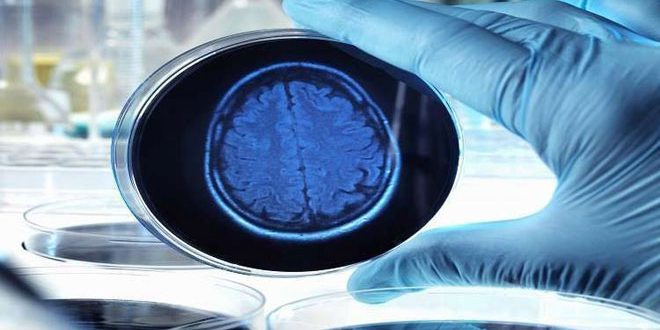

واشنطن-سانا
طور علماء أمريكيون فحصا جديدا للدماغ يهدف إلى الكشف المبكر عن مرض الزهايمر وأعراضه.
وذكرت صحيفة ديلي ميل البريطانية أن باحثين من جامعة جونز هوبكنز الأميركية طوروا علاجا يقضي بحقن جزيئات إشعاعية في الجمجمة بهدف إضاءة لوحات ترتبط بالبروتين في الدماغ والذي يعتقد أنه المسؤول عن التدهور المعرفي.
وأوضح كبير الباحثين في الدراسة الدكتور دين وونج أن البروتينات تشكل مجموعة من الكتل تخنق وتدمر الخلايا العصبية ما يؤدي إلى فقدان الذاكرة والإصابة بالزهايمر مبينا أن إحدى أكبر المشكلات في دراسة الزهايمر هي عدم القدرة على مشاهدة هذه البروتينات في الوقت الحقيقي لكن عبر هذا الفحص الجديد يمكن رؤية البروتينات وتحديد مكامن الخلل في الدماغ في حال توافرها.
ووفق آخر إحصائيات لعام 2018 فإن نحو 7ر5 ملايين أميركي من مختلف الأعمار يعانون من مرض الزهايمر ويتوقع أن يرتفع هذا العدد إلى 14 مليون بحلول عام 2050.
S A N A الوكالة العربية السورية للأنباء